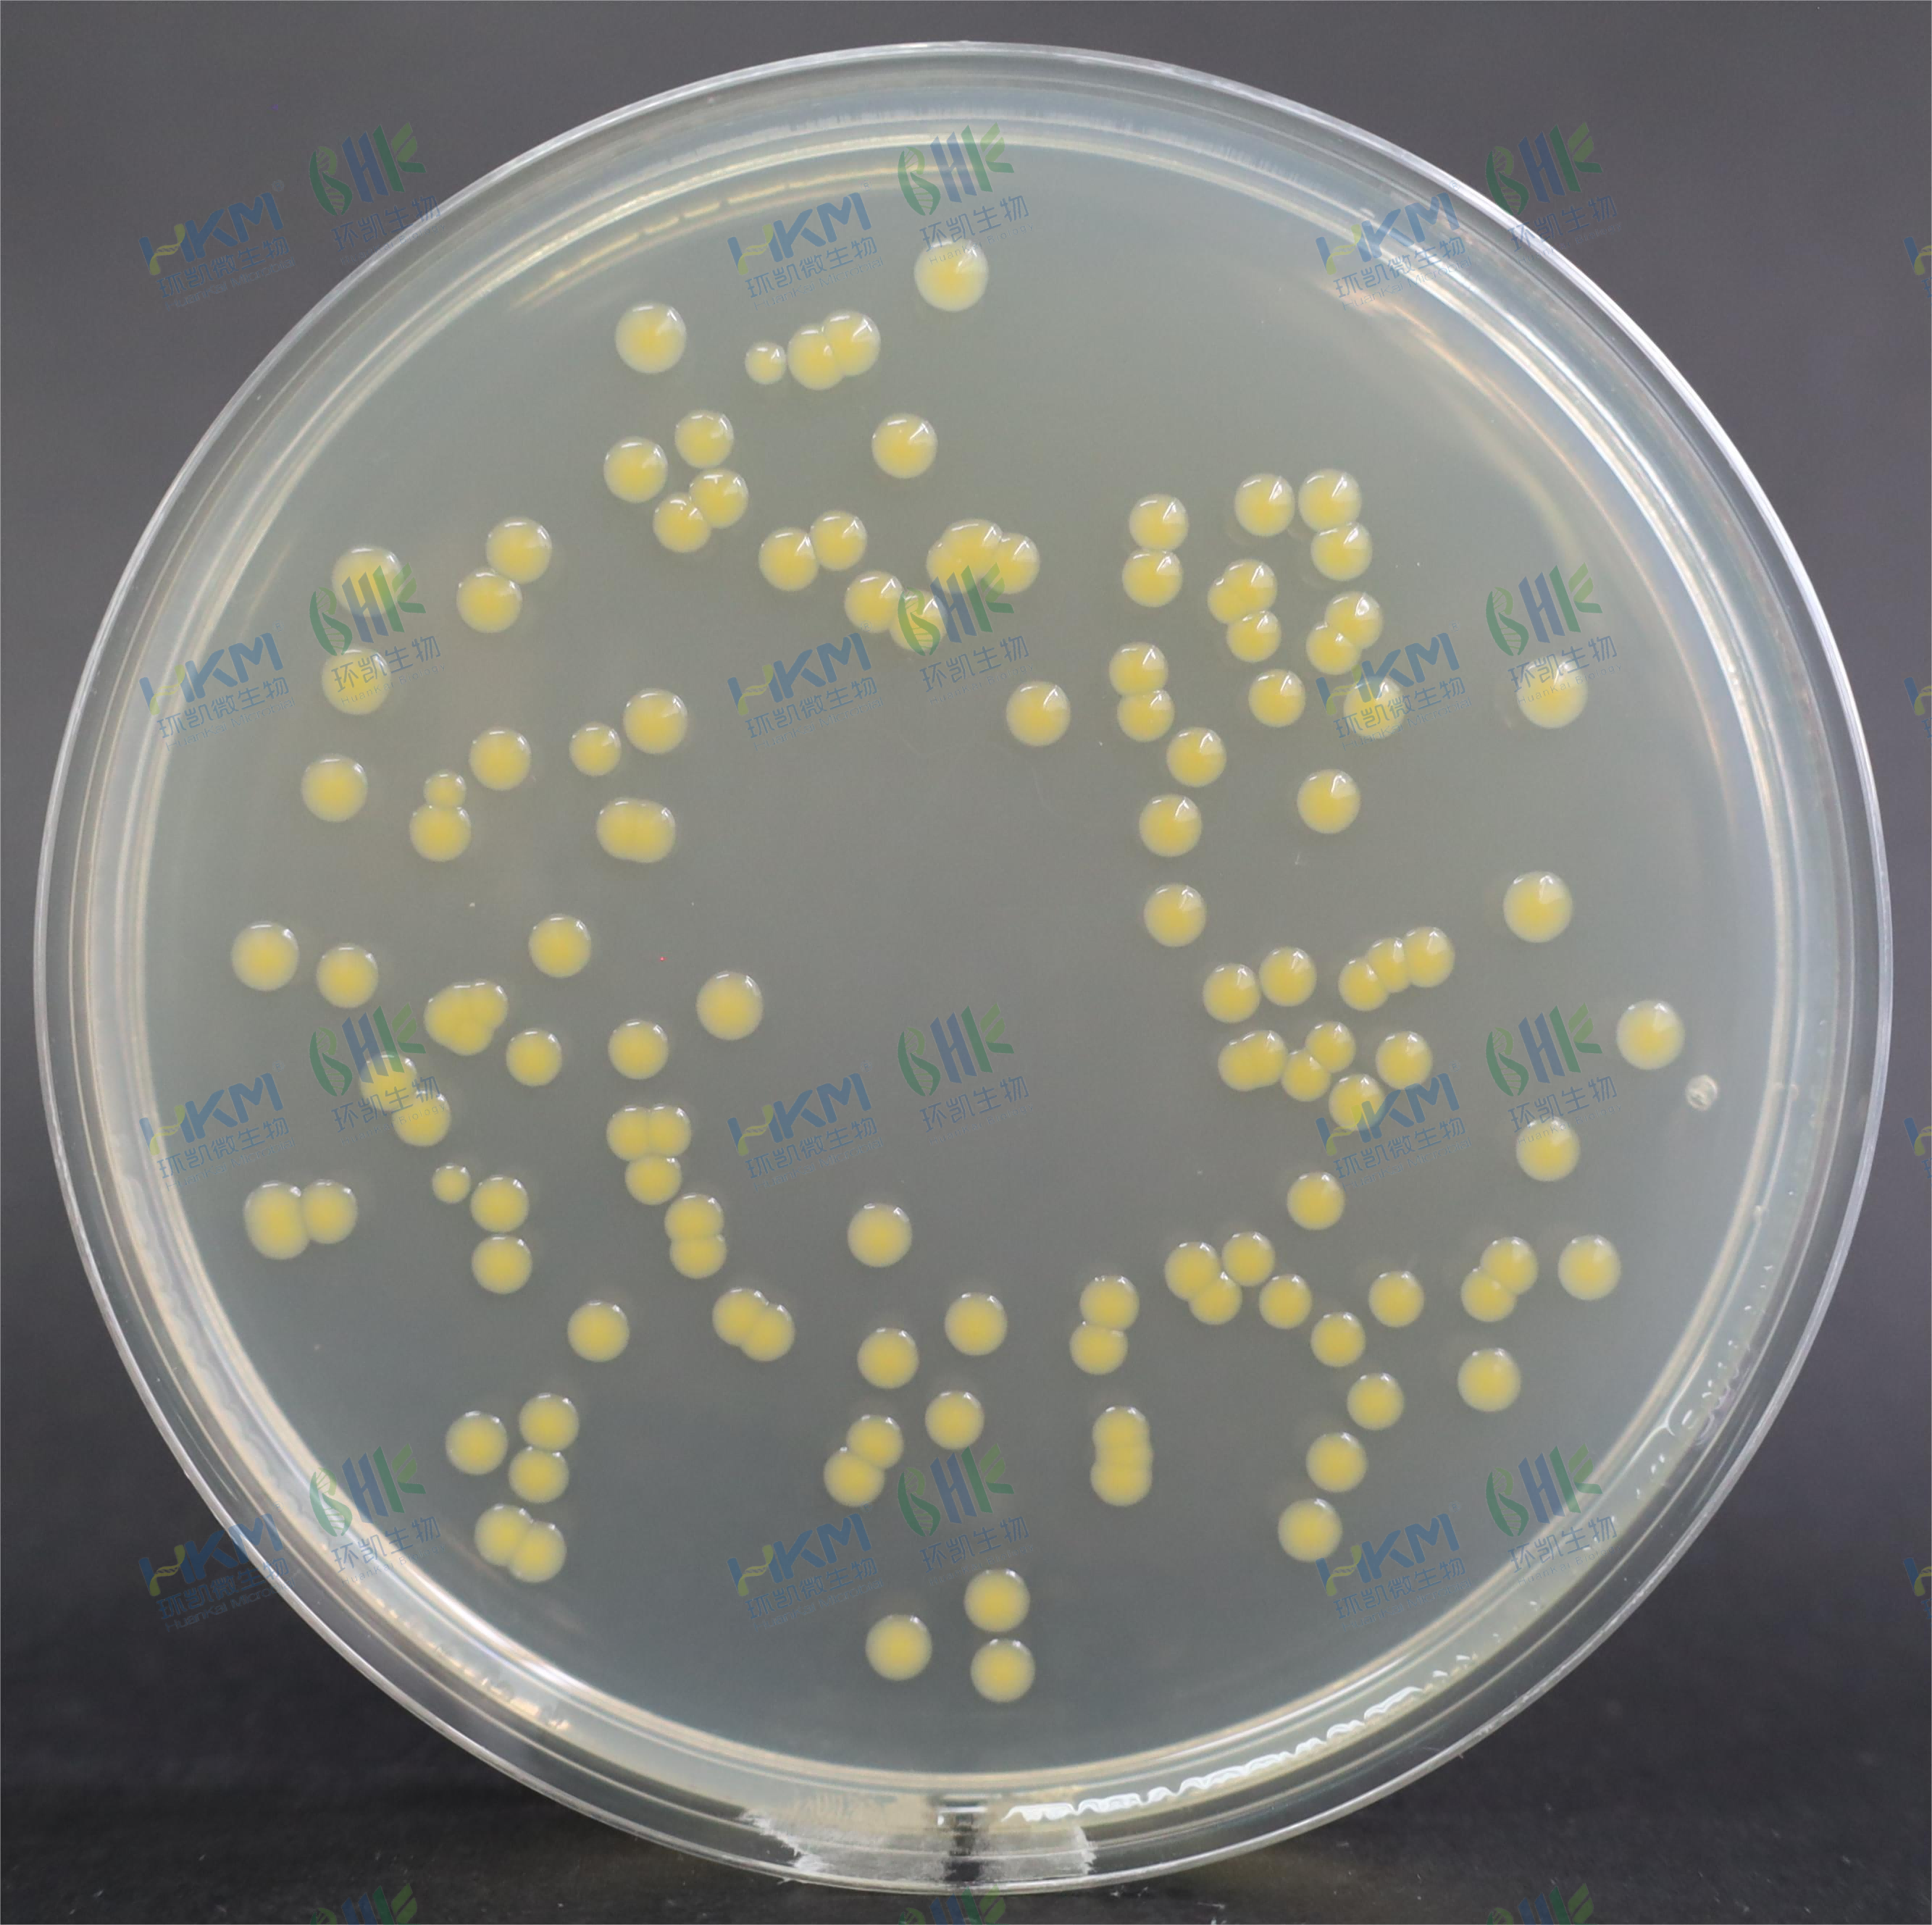
莫氏克罗诺杆菌CMCC（B）45407
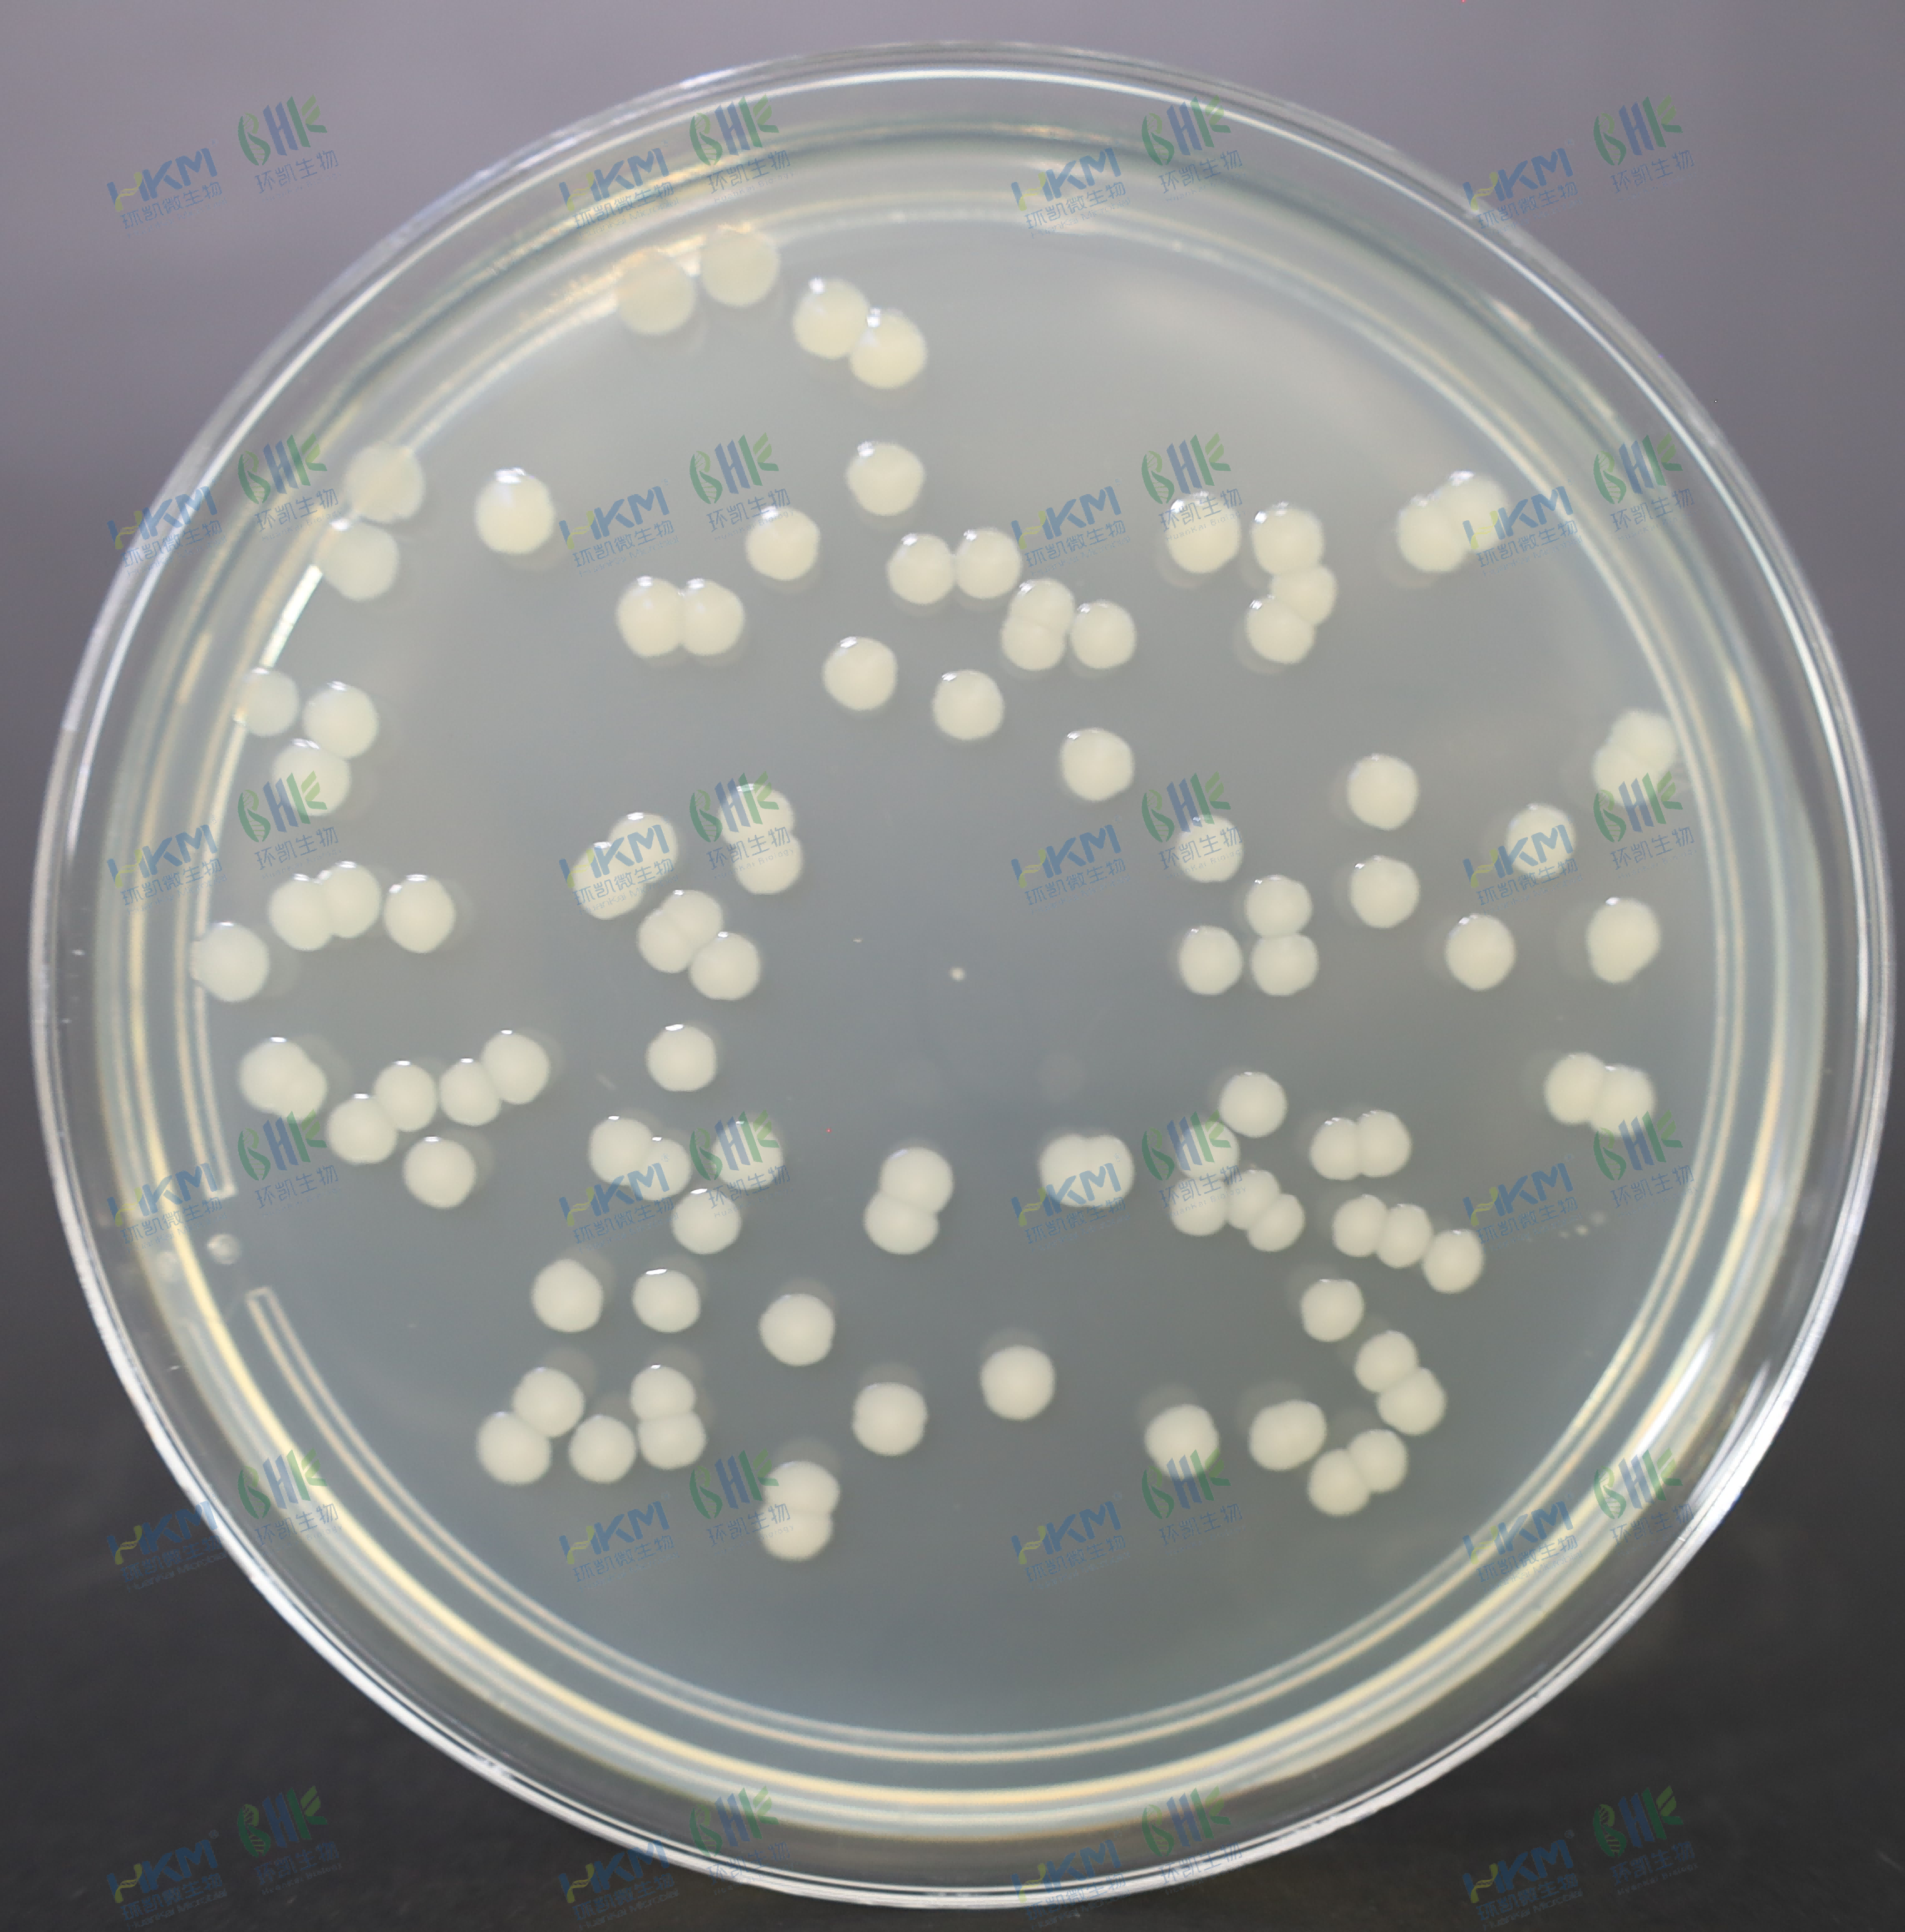
大肠埃希氏菌CMCC（B）44102
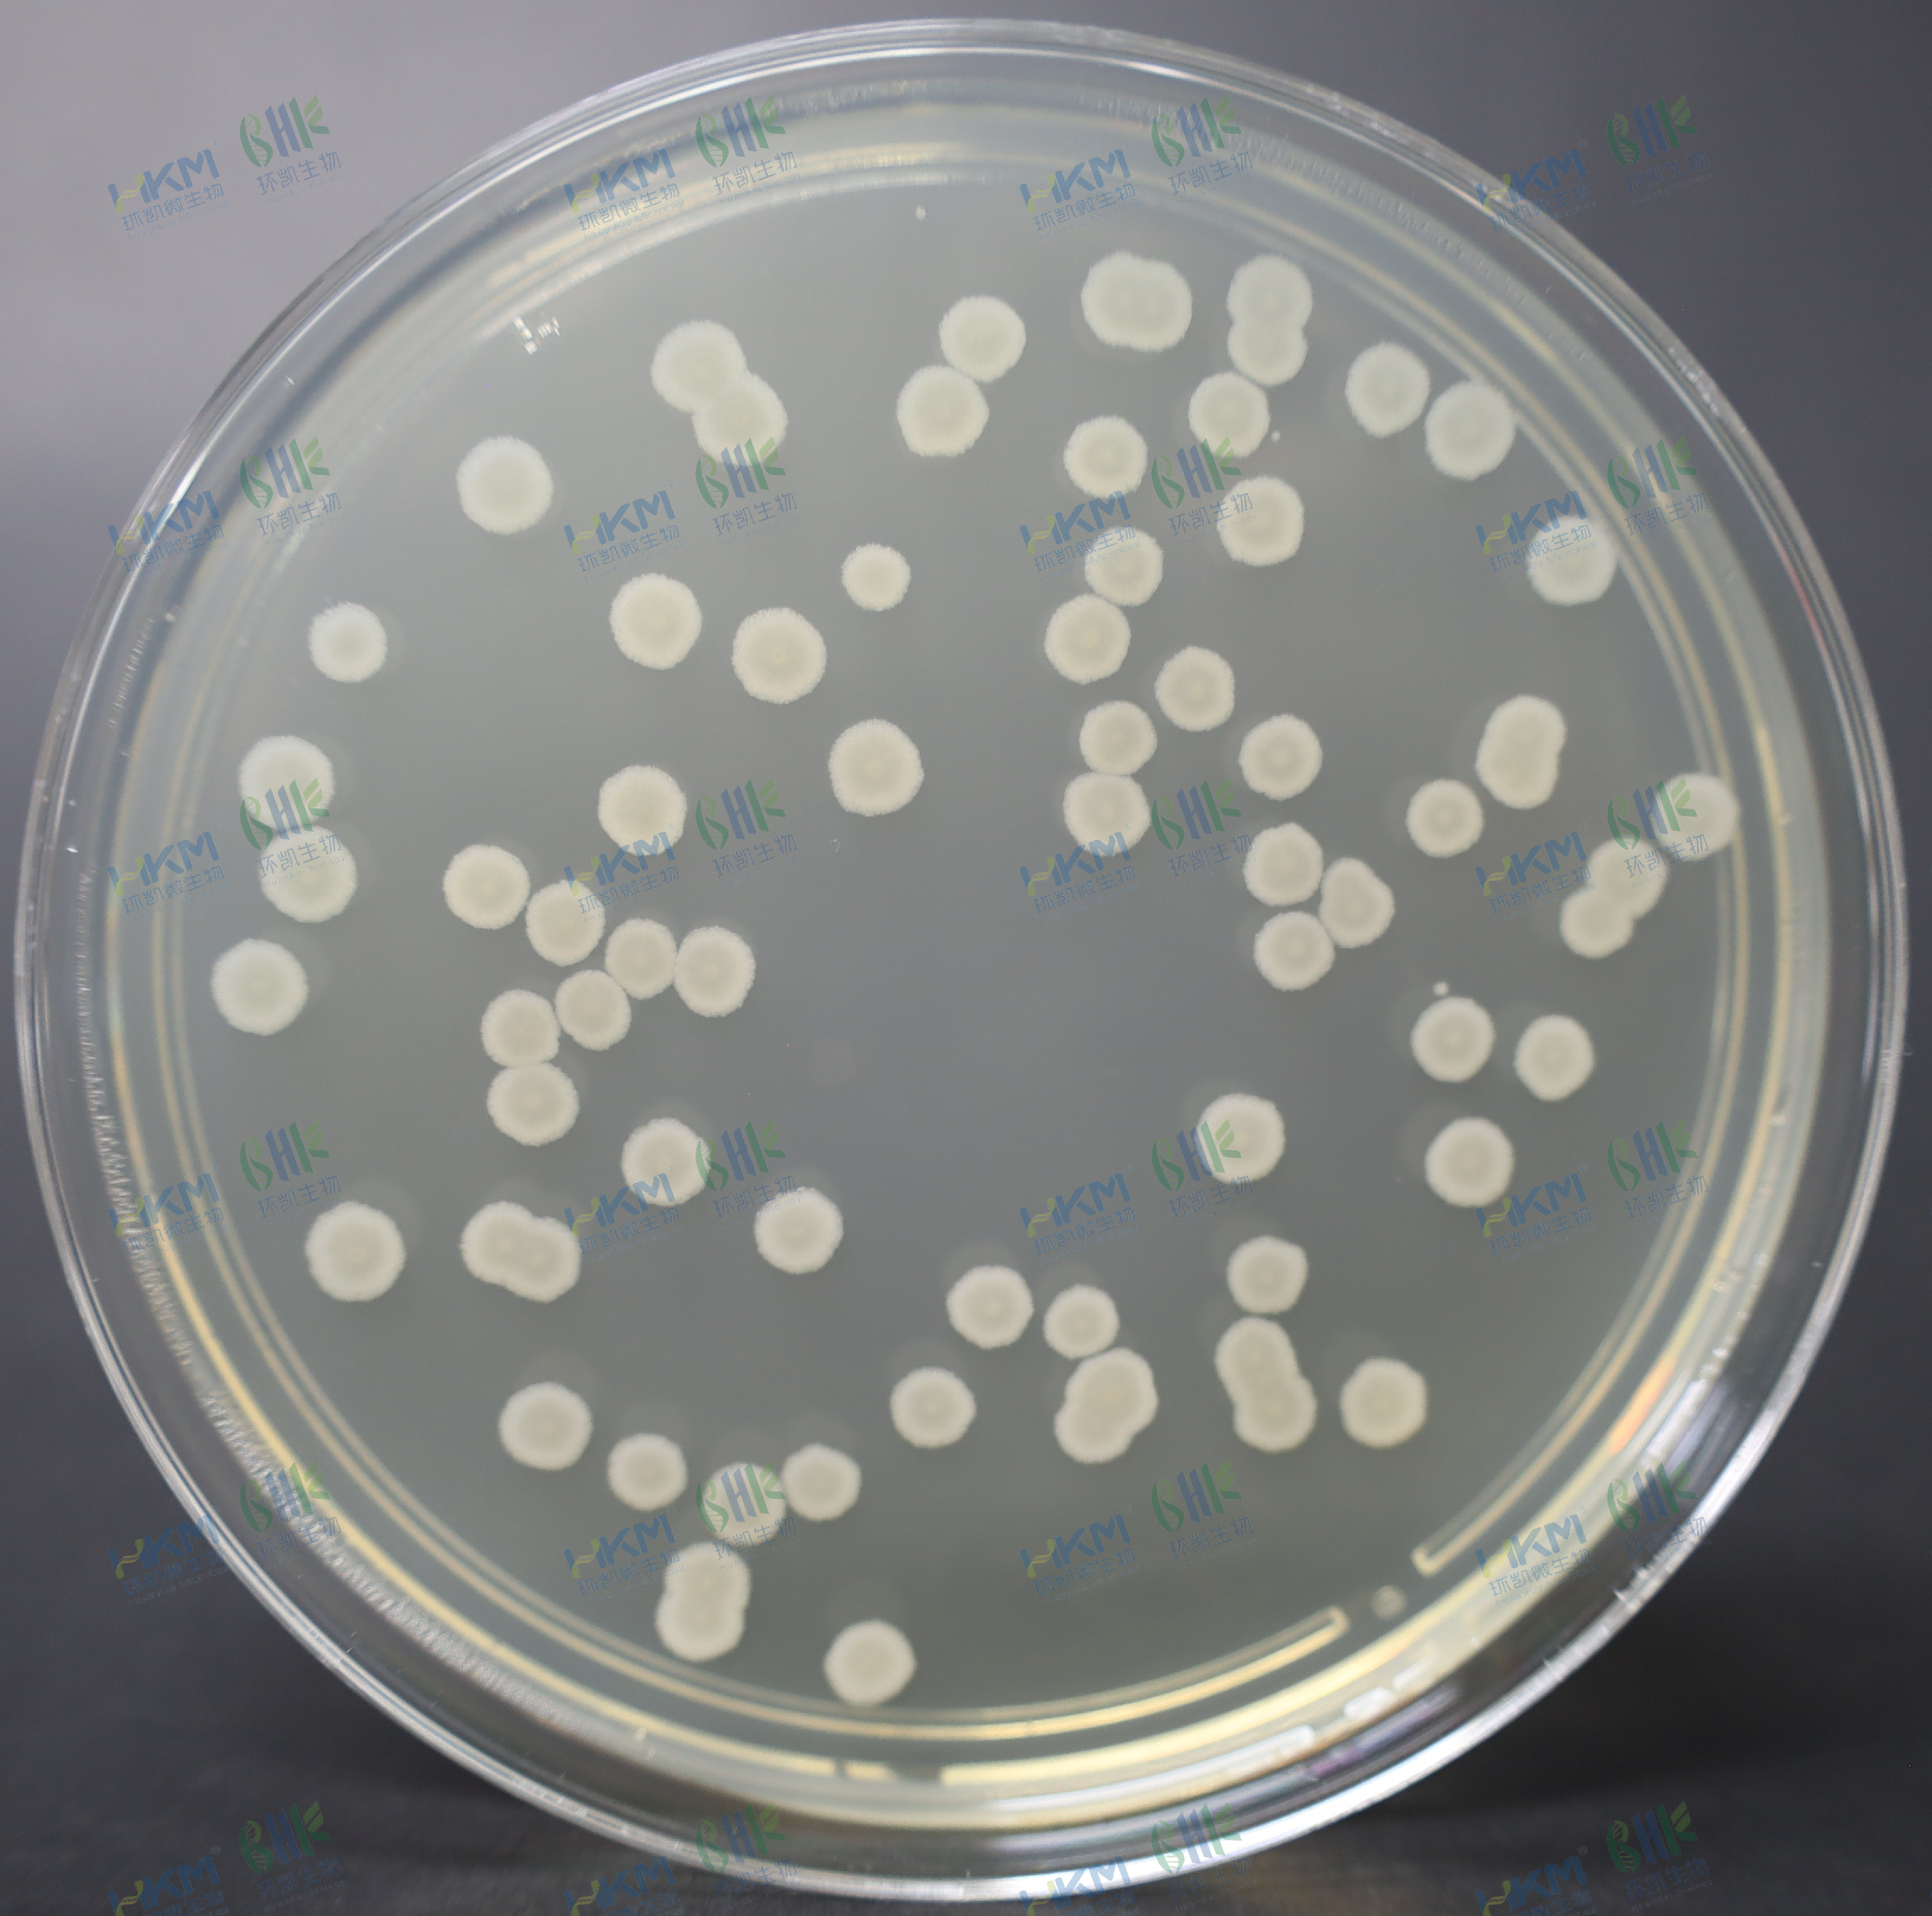
枯草芽孢杆菌CMCC（B）63501
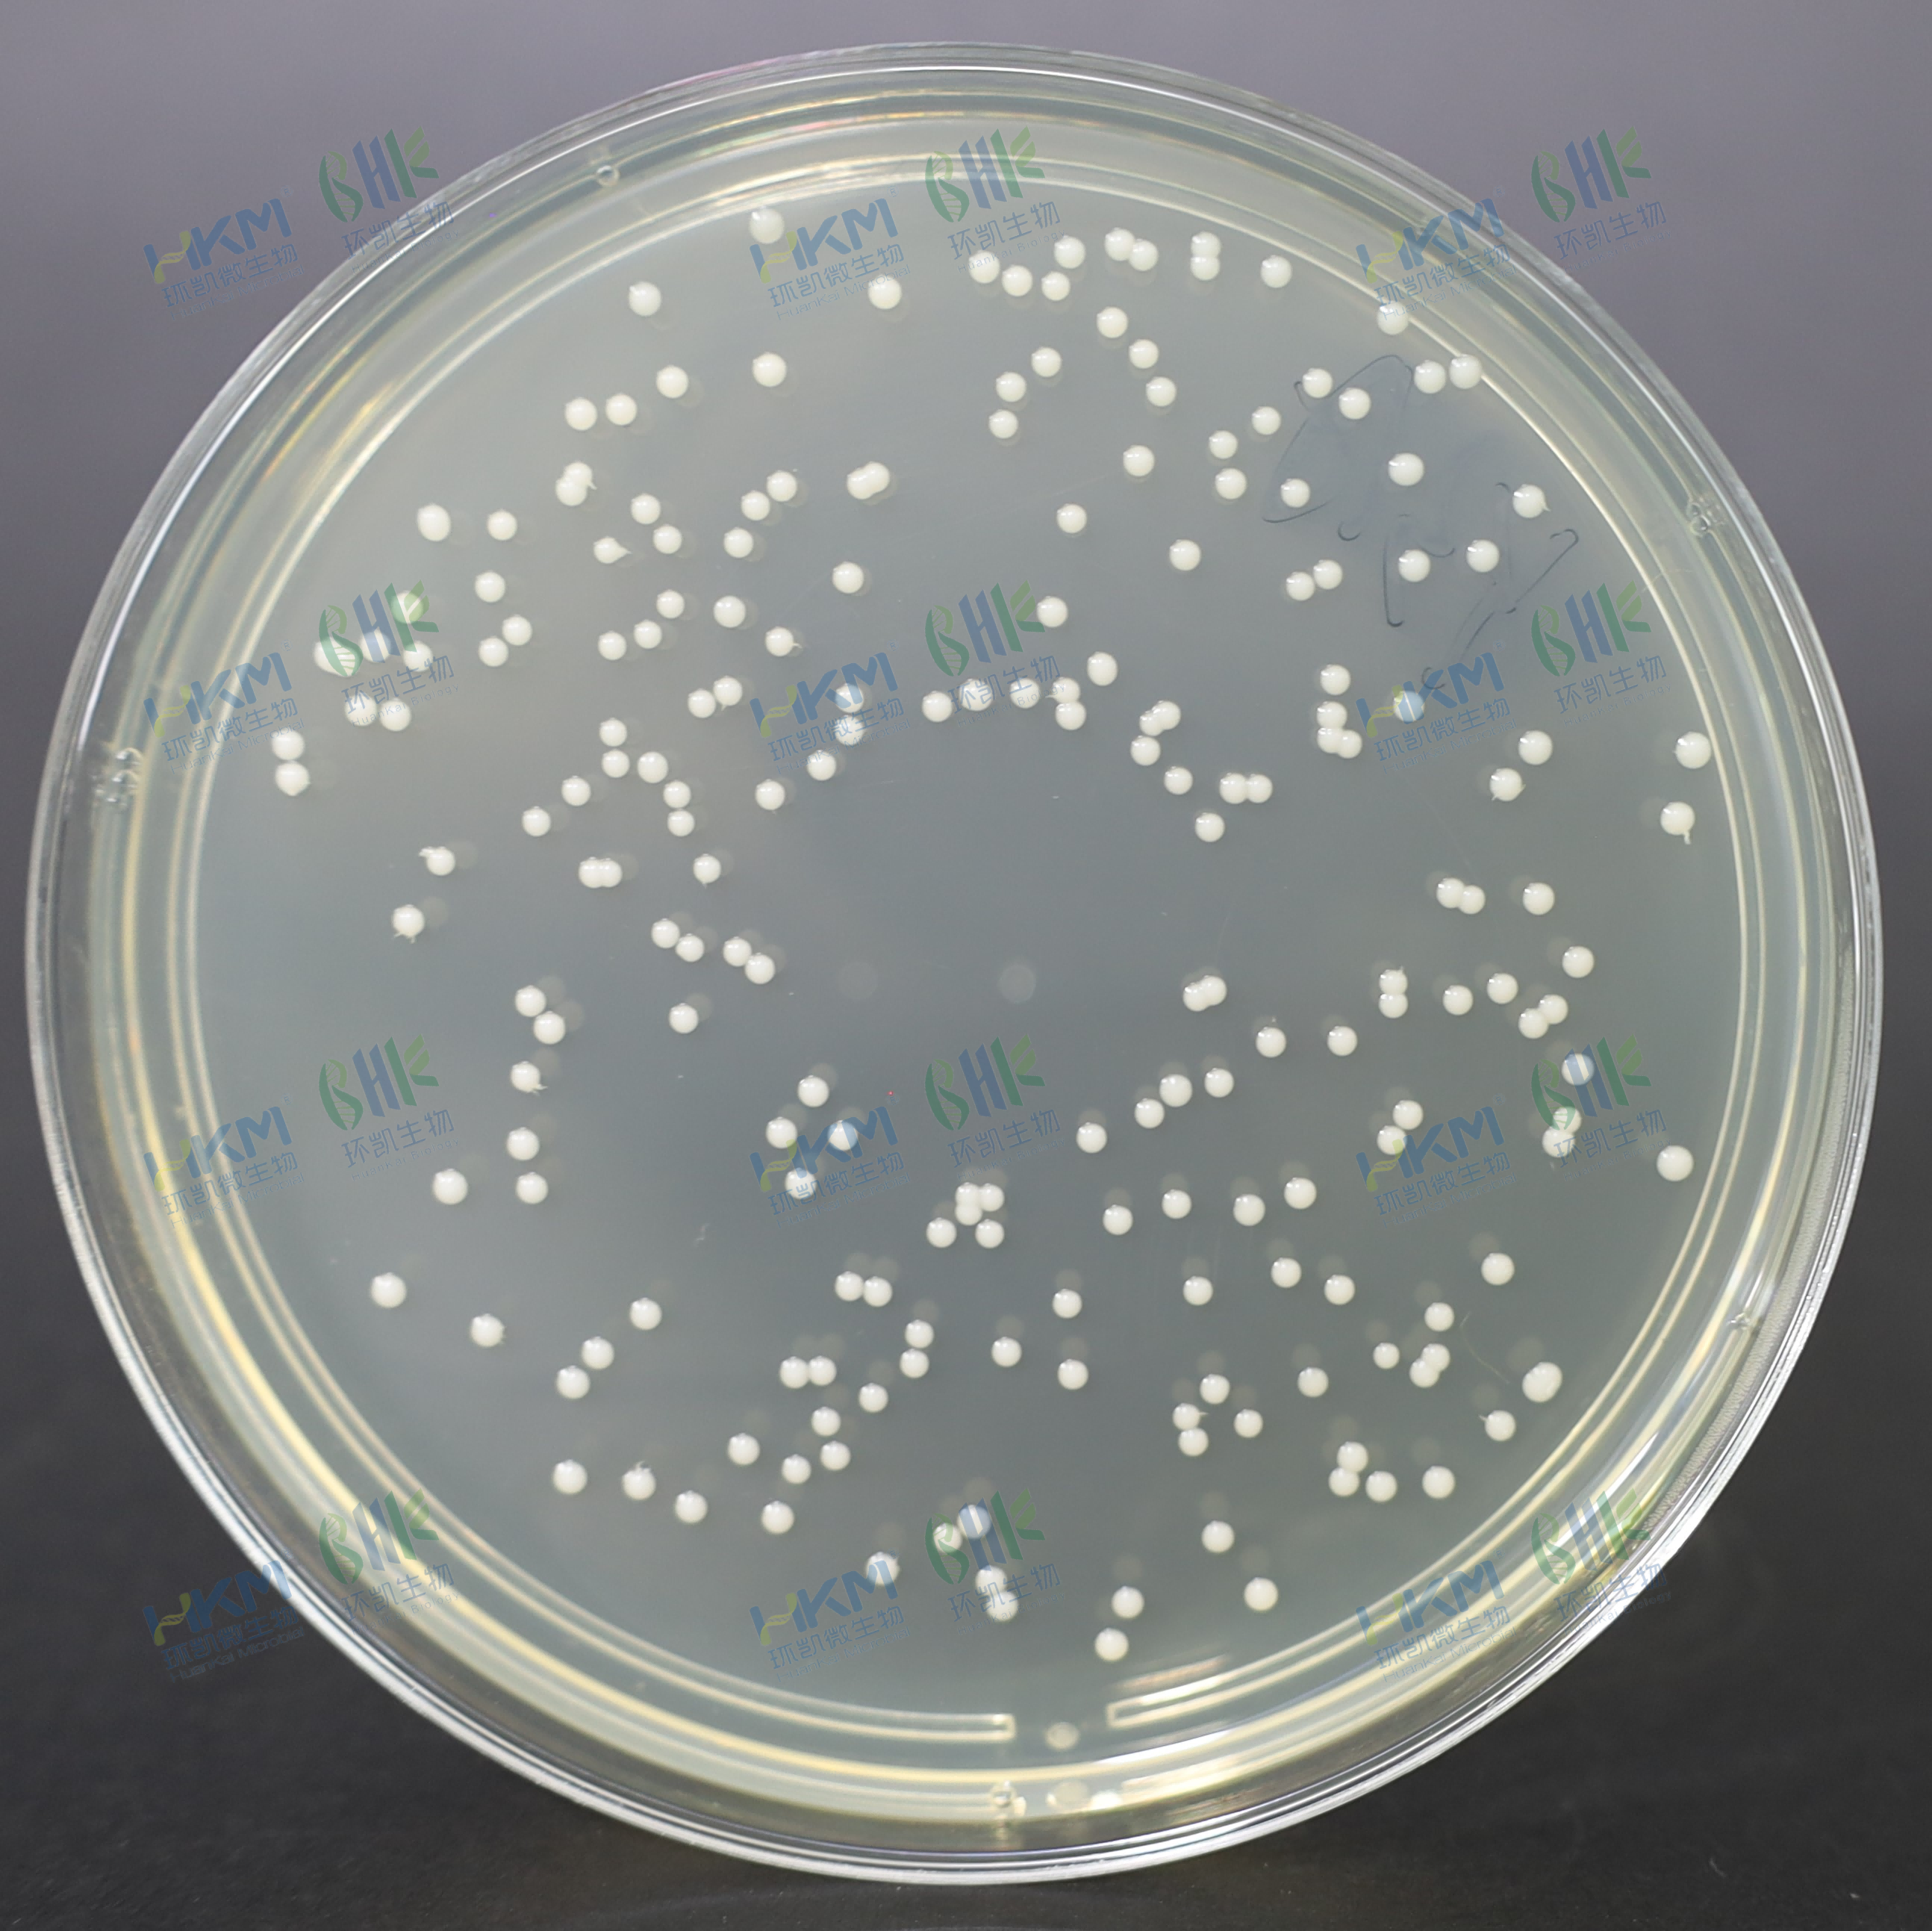
白色念珠菌CMCC(B）98001
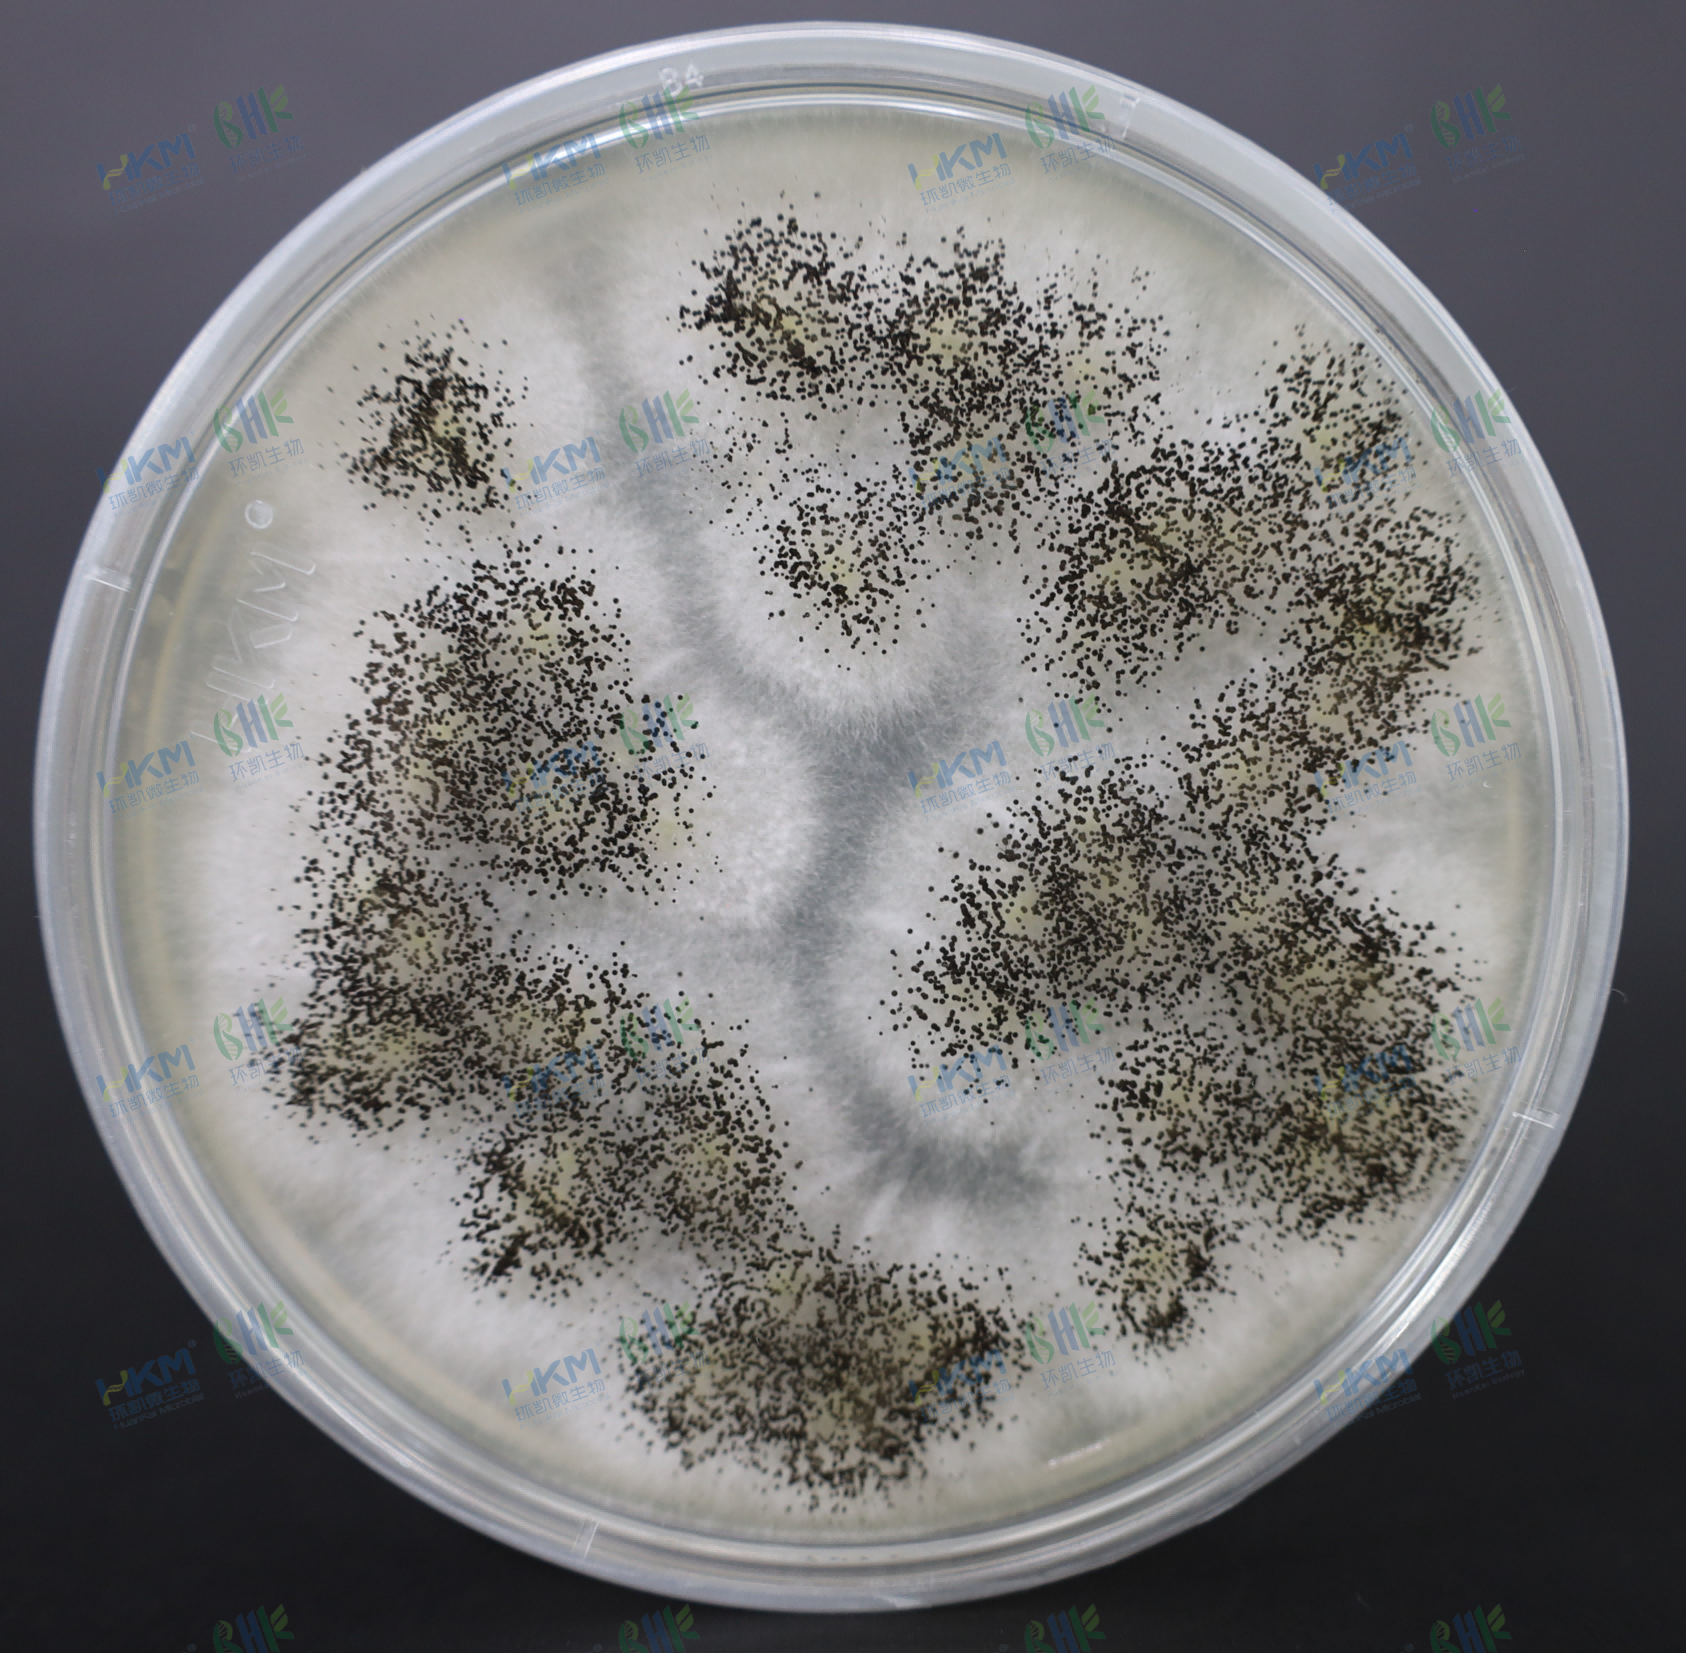
黑曲霉CMCC(F）98003
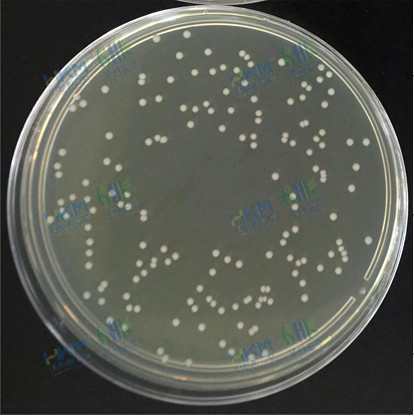
粪肠球菌CMCC(B)32480
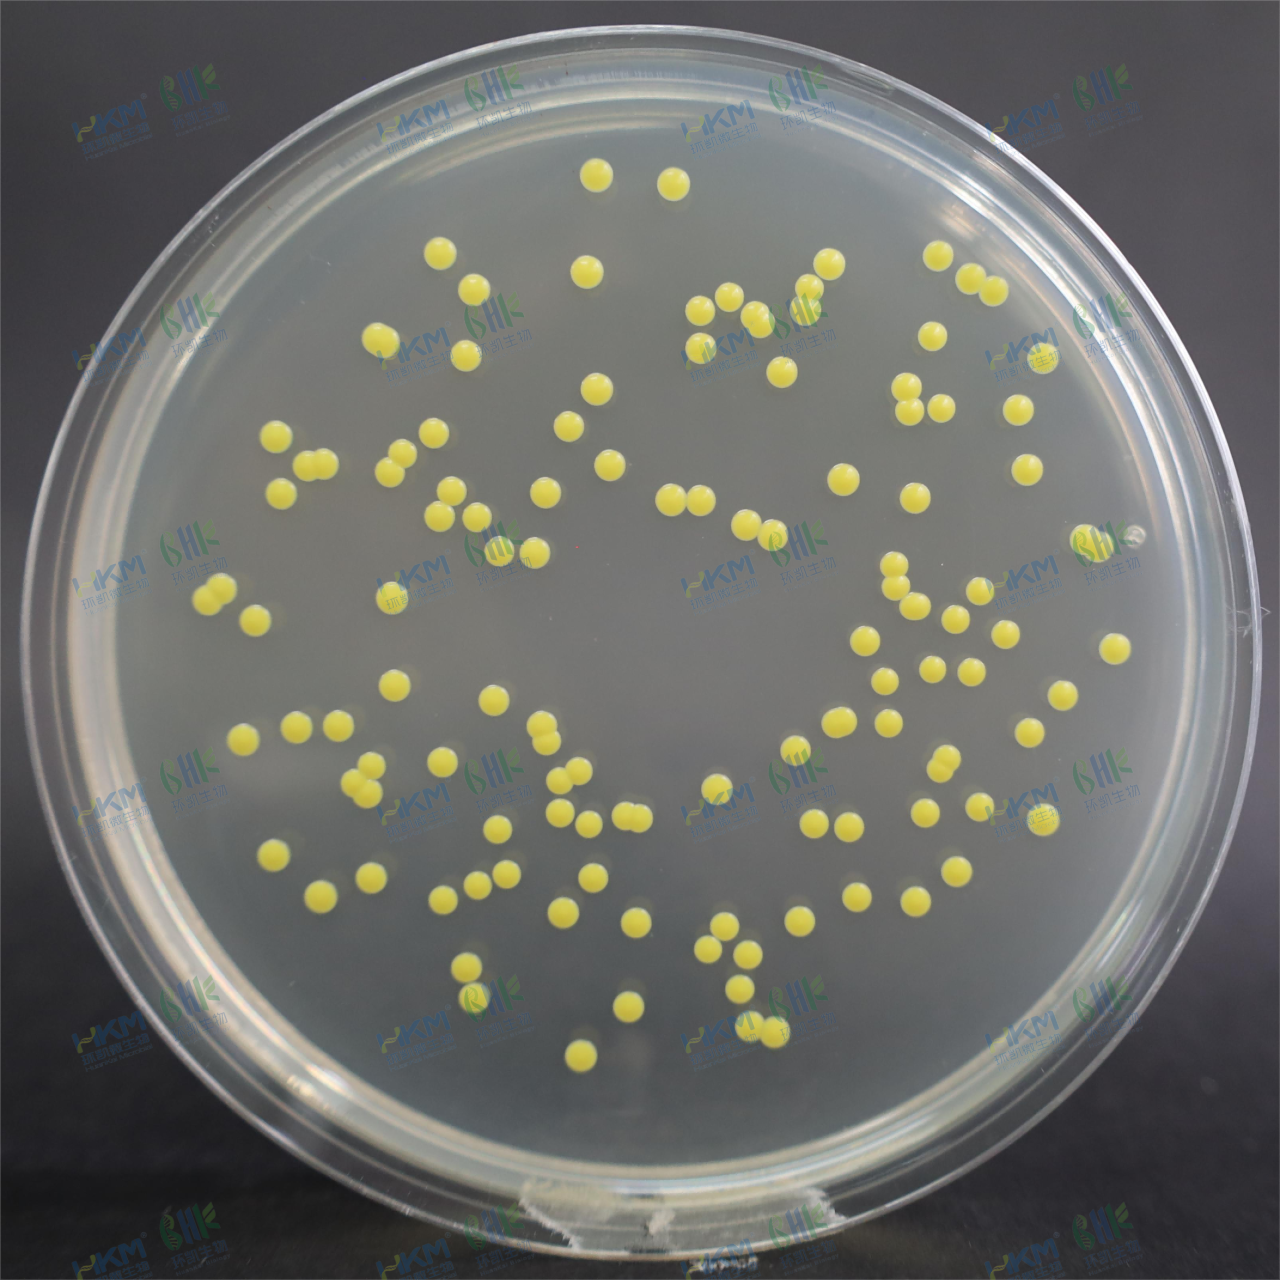
藤黄微球菌CMCC(B)28001
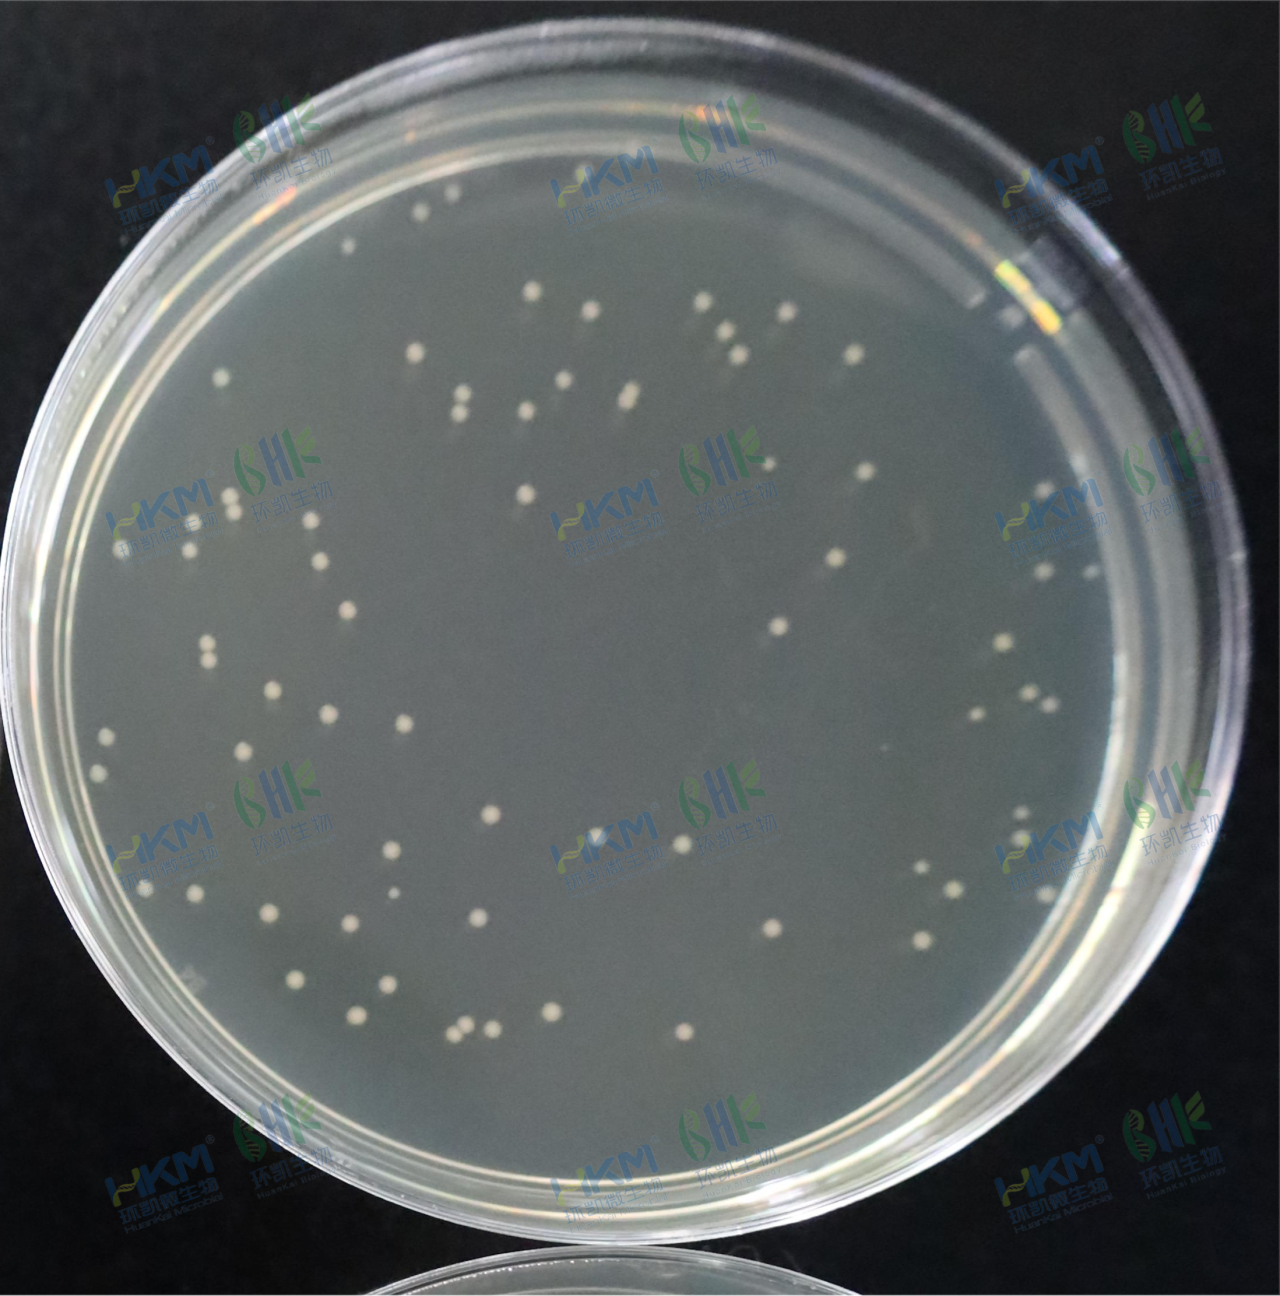
嗜热嗜脂肪地芽孢杆菌CMCC(B)63509

GB4789.28-2024参比培养基质控解析及图谱——TSA篇
发布时间:2025-05-08 浏览次数:7443
随着2024年年初GB4789.28-2024重磅发布,随之各地掀起了标准学习的热潮,参比培养基质控标准的加入,也成为了此标准的一大亮点,作为在此标准中起着绝对“标杆”作用的参比培养基,其质控方法、质控要求也受到业内同仁的一致追捧,今天小编就跟大家一起来聊一聊参比培养基的质控。文章附有培养基质控菌高清无码图片奥,一定要看到底!
参比培养基是为保证食品微生物检验用培养基的质量而存在的,凡琼脂培养基,无论是非选择性的还是选择性的,其涉及生长率的测试均需用到参比培养基。参比培养基作为回收率计算的“分母”,其质量优劣对培养基的验收工作至关重要。今天就胰蛋白胨大豆琼脂培养基(Trypticase Say Agar,TSA)参比培养基的质控进行解析,一起来看看吧。
第一,需核对参比培养基标准配方,如图所示;

第二,参比培养基需由具备相应检验能力,并取得通过国家认证认可资质检验机构出具的检测报告。
第三,应满足相关理化指标要求:外观要求为淡黄色粉末,灭菌后为淡黄色透明胶体。PH值控制在灭菌后冷却至25℃时7.3±0.2的范围内。
第四,微生物指标,标准中规定的TSA参比培养基测试菌株为10株,对于参比培养基的微生物促生长检测项目,GB4789.28中规定的质控评定标准中的要求如下:

如何操作呢?
GB4789.28-2024中原文“参比培养基具体检验方法可参考6.1或6.2.3”,那么6.1和6.2.3分别是什么呢?章节6.1为“非选择性分离和计数固体培养基目标菌生长率定量测试方法”对非选择性的参比培养基TSA具有操作上的指导意义!章节6.2.3为“非目标菌(特异性)定性测试方法”,而TSA/SDA/MRS中测试菌种均涉及其促生长能力,为相应培养基的目标菌,在此6.2.3测试方法不适用于参比培养基的测试方法。
测试方法具体操作如下:
1、工作菌悬液的制备:将标准储备菌株、储备菌株或工作菌株接种到非选择性肉汤培养过夜或采用其他方法,制备10倍系列稀释的菌悬液。进行生长率测试时,细菌和酵母菌每平板的接种水平为50CFU~250CFU,霉菌每平板的接种水平为30CFU~150CFU。
2、接种:选择适宜稀释度的工作菌悬液0.1mL,均匀涂布接种于待测平板和参比平板。每一稀释度接种两个平板。也可使用螺旋涂布法或倾注法进行接种,并按标准规定的条件培养。
【倾注法,菌落长在琼脂内部和表面,其形态不便统一。这里不使用倾注法,而选用螺旋法,也可使用涂布法。个人觉得,倾注法的最佳使用范畴,可以在验收平板计数法用的培养基时考虑使用此法验收,而当培养基做为划线分离或者涂布使用时,优先考虑涂布或螺旋法验收培养基。】
为了直观了解到其测试菌株在TSA参比培养基上的具体菌落形态,小编现将试验菌落特征图列于下表:
| 菌株名称及编号 | 培养条件 | 接种量/cfu | 菌落特征图 | 实验结果 |
|---|---|---|---|---|
| 莫氏克罗诺杆菌CMCC(B)45407 | 25℃,48h | 117 | | 生长良好,菌落黄色,圆形,表面光滑,湿润。 |
| 大肠埃希氏菌CMCC(B)44102 | 36℃,24h | 99 | | 生长良好,菌落灰白色,圆形,表面光滑,湿润 |
| 金黄色葡萄球菌CMCC(B)26003 | 36℃,24h | 54 |  | 生长良好,菌落淡黄色,圆形 |
| 枯草芽孢杆菌CMCC(B)63501 | 36℃,24h | 71 | | 生长良好,菌落灰白色,圆形,干燥 |
| 白色念珠菌CMCC(B)98001 | 28℃,72h | 206 | | 生长良好,菌落白色,圆形,表面光滑,湿润 |
| 黑曲霉CMCC(F)98003 | 28℃,72h | 39 | | 生长良好,产黑色孢子 |
| 粪肠球菌CMCC(B)32480 | 36℃,24h | 159 | | 生长良好,菌落白色,圆形 |
| 藤黄微球菌CMCC(B)28001 | 36℃,48h | 119 | | 生长良好,菌落浅黄色,圆形 |
| 嗜热嗜脂肪地芽孢杆菌CMCC(B)63509 | 56℃,24h | 71 | | 灰白色,圆形,表面光滑,湿润 |






